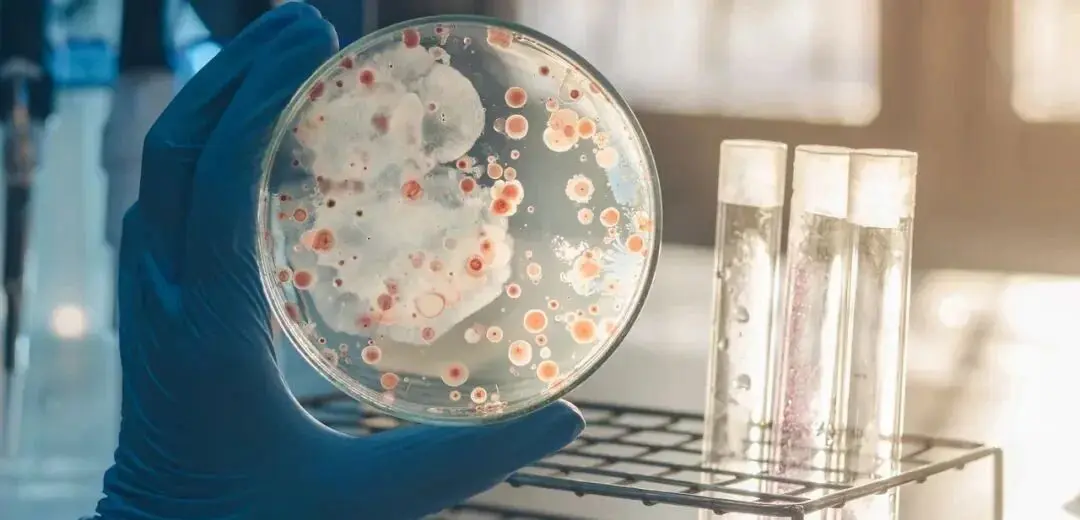
细菌培养
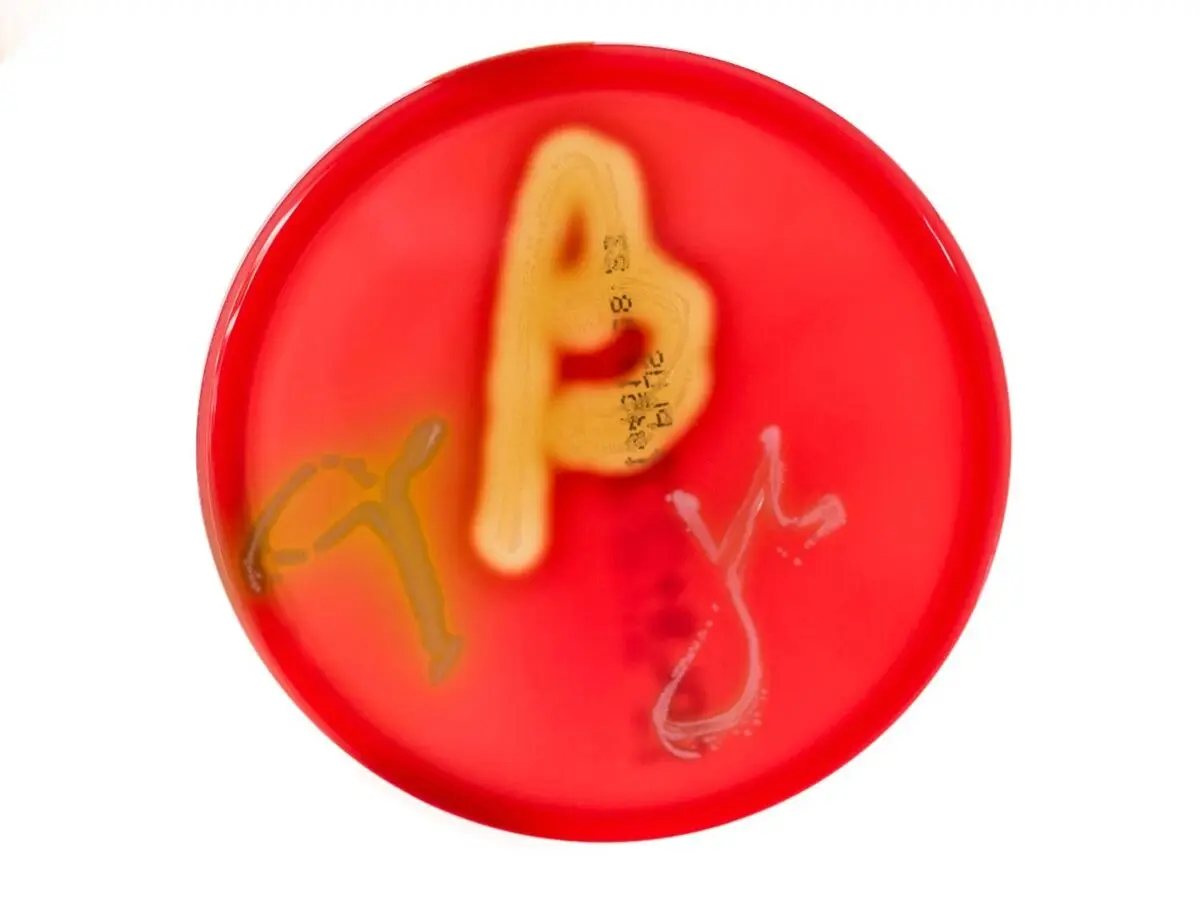
血琼脂培养显示的 α（左）、β（中）和 γ（右）溶血

细菌培养:定义、条件、营养、速率、获取、步骤及常见问题
发布时间:2025-12-01 浏览次数:649
细菌培养(bacterial culture)是一种在受控实验室条件下,通过培养基使细菌细胞在培养基内部或表面增殖的方法。实现最佳增殖所需的具体条件取决于目标菌种。
细菌培养涉及诸多复杂因素,其应用场景广泛,培养来源多样,不同菌种在生长需求方面存在显著差异——某些菌种对生长条件的要求尤为苛刻。当尝试从混合菌群中分离特定菌株时,研究复杂性将进一步加剧,因为部分菌种在竞争中会展现出显著优势。
为确保细菌培养实验的成功率,选择适配的实验培养条件至关重要,同时需通过规范的无菌操作技术有效避免污染风险。
本文梳理了细菌培养过程中需重点考量的因素,帮助大家快速入门细菌培养。
一、细菌培养的目的?需氧培养与厌氧培养的区别是什么?
细菌培养可实现:
从混合样本中分离特定菌株。例如:用于感染病原诊断。通过对伤口进行拭子采样,从正常皮肤菌群中分离致病菌。
确定抗生素敏感性。例如:用于指导临床治疗。在成功分离致病菌株后,关键步骤在于明确何种抗生素适用于针对性治疗。
对细菌菌株进行遗传学操作。例如:实施基因突变或缺失实验。这是基础研究中(如基因功能解析及疫苗研发等领域)分子生物学研究的关键步骤。
将细菌作为分子生物学研究工具。例如:目标蛋白的规模化表达。将强启动子调控下的蛋白编码基因导入大肠杆菌实验室菌株,可将其转化为微型蛋白生产系统。
应用于食品及饮料制造领域。例如:发酵工艺、奶酪制作及益生菌制剂生产。正是细菌对乳制品等原料的作用赋予了其独特风味,同时此类微生物代谢产物对人体健康具有积极影响。
需氧培养与厌氧培养的区别
多数细菌在氧气存在时(即需氧培养)可一定程度生长,但需调整条件以满足目标菌的最适生长需求。通常存在于大气环境(如皮肤表面或上呼吸道)的菌种在氧气存在时生长良好;而天然存在于低氧环境(如深部伤口、脓肿或深海)的菌种则在无氧条件(厌氧培养)下生长最佳。部分菌种完全无法在氧气存在时生长,称为专性厌氧菌,例如梭杆菌属和拟杆菌属。同理,无法在无氧条件下生长的菌种称为专性需氧菌,培养实例包括革兰氏阴性菌铜绿假单胞菌和结核分枝杆菌(结核病的病原体)。但研究表明,二者在特定条件下均可进行厌氧呼吸。

需氧菌和厌氧菌的区别
能够在需氧或厌氧条件下生长的细菌(当氧气缺乏时从需氧呼吸转换为发酵或厌氧呼吸)称为兼性厌氧菌,例如革兰氏阳性葡萄球菌、大肠杆菌(E. coli)、沙门氏菌属和李斯特菌属。
二、细菌培养基简介
要成功培养细菌,需在培养基中提供营养物质。现有多种配方可满足不同菌种的营养需求。培养基类型的选择取决于培养目的:富营养培养基或完全培养基有助于扩增纯培养物并维持细菌细胞良好状态;而基本培养基仅提供生存必需的最低营养,可用于调控细菌代谢通路的开启。
培养基还可划分为明确成分与不明确成分两类。顾名思义,明确成分培养基的所有组分均为已知物质;不明确成分培养基通常含有未知比例的复杂营养混合物(如酵母提取物)。无论选择何种培养基,均可制备为液态的肉汤培养液,或通过添加琼脂形成固体培养基以供细菌在固体表面生长。
肉汤培养液(broth culture)
液态培养基(即肉汤培养液,常见的如分子生物学中的LB培养液)可使细菌更易接触营养物质,相较于静态菌落更具优势。孵育期间轻柔振荡使细菌均匀分散于培养基中,可进一步促进营养吸收。液态培养基还能稀释代谢废物并使其均匀分布,因此在同等体积下,液态培养基可培养的细菌生物量通常高于固体培养基。

液体培养基
肉汤培养液适用于大规模培养细菌的场景,例如利用细菌生产特定化合物、食品加工或提取DNA/质粒。若需长期保存菌株,可先在液态培养基中扩增菌体,随后添加甘油以防止细菌完全冻结及细胞裂解,从而实现菌株在-80°C条件下的长期保存。此类保存方式不仅适用于长期菌种收集,还能避免珍贵菌株的丢失,并减少因反复传代导致的突变风险。
营养琼脂(Nutrient agar)
向液态培养基添加琼脂可制成平皿培养基、斜面培养基或穿刺培养基等固体形式。固体培养基适用于从混合培养物中筛选单一菌落(如临床样本纯化),或通过平板计数法测定液体样本中菌落形成单位(CFU)的数量。利用斜面或穿刺培养也是实验室间安全运输菌株的常用方法,可避免潜在感染性物质的泄漏风险。

营养琼脂
选择培养基与鉴别培养基(Selective and differential media)
选择性培养基可促进或抑制特定菌种、菌群或具有特定特性的菌株生长。其原理基于菌株对特定营养的利用能力、代谢副产物的生成或抗生素抗性等特性。选择性培养既可用于液态培养基,也可用于固态培养基。
鉴别培养基通过颜色变化指示菌株的生长能力,常用于菌种或亚型的鉴定。例如,API(分析特性指数)测试条通过细菌对多种底物的代谢反应产生差异化的显色模式实现鉴定。若菌株具有溶血性,血琼脂培养基可评估其溶血类型(α、β或γ型),辅助菌种鉴定(下图)。
血琼脂培养显示的 α(左)、β(中)和 γ(右)溶血
在液态培养基中添加抗生素可抑制非抗性菌株生长,适用于携带抗生素抗性标记基因的工程菌株培养,从而筛选出未成功改造的污染菌株或菌落。
固体培养基中可直接添加抗生素,或放置含抗生素的纸片。若菌株对抗生素敏感,纸片周围会出现抑菌圈(下图),此方法可用于临床感染治疗中抗生素的选择。例如,下图左侧培养物中的细菌对白色纸片所含抗生素敏感,而右侧培养物中的细菌对多数抗生素具有抗性。

抗生素耐药性测试
三、细菌生长速率
除氧气条件和营养需求外,不同菌种的最适生长温度和湿度也因其自然生境而异。通常存在于体内深部环境(如肠道或下呼吸道)的菌种最适生长温度为37°C(体温);而土壤来源的菌种往往需要较低温度。在细菌基因操作中,温度可作为调控工具,通过温度敏感性质粒的整合控制实现目标产物的定向表达。
细菌生长曲线
尽管不同细菌物种的分裂速率存在差异,但它们在液体培养中通常遵循相同的总体生长模式。培养物中的细菌数量可通过多种方法估算,包括平板菌落计数法或利用紫外-可见分光光度法测定培养液浊度。当以时间为横轴(通常采用对数刻度)绘制该数值时,即可获得生长曲线(下图)。

细菌生长曲线示例:分别为1)滞后期;2)指数期(对数期);3)稳定期;4)衰亡期
延滞期 —— 细菌正在适应新的生长环境。此阶段时长取决于新环境与原生长条件的相似性及细胞状态。细菌可能需要自我修复、合成复制所需的酶和RNA,或生成环境中缺乏的特定分子。
指数期(对数期) —— 一旦细菌适应环境并获得所需分子,细胞分裂将正式启动。此阶段遵循可预测的倍增规律,倍增时间取决于环境条件对目标菌种的适宜程度。当条件接近最适状态时,细菌快速生长,曲线呈现陡峭上升趋势。此阶段的细菌细胞状态最佳,因此通常被选作后续实验的材料来源。
稳定期 —— 营养物质逐渐耗尽,代谢废物积累且空间受限,导致新细胞生成速率与死亡速率持平,生长曲线趋于平缓。细菌细胞发生生理变化以适应营养匮乏状态。对于产芽孢菌种,此阶段可能启动芽孢形成。
衰亡期 —— 当环境不再支持生长时,细胞状态持续恶化,生长曲线呈下降趋势。非存活细胞仍会导致浊度测量值偏高(若通过浊度估算细胞数量),使测量值高于实际活菌数。通常情况下,部分细胞通过突变或进入休眠状态维持存活,从而在培养物中持续存在。
四、纯培养物的获取
纯培养物是指仅含目标菌种的培养体系。其获取难易程度主要取决于样本来源、目标菌种与其他菌种的相对丰度及目标菌种自身特性。若样本源自已有的纯培养物或经分离冷冻保存的菌株,则培养体系可能已为纯培养。然而,若样本为临床或环境来源,则可能含有多种共存细菌甚至真菌,这些微生物在相同培养条件下均可旺盛生长。选择性培养基与限制性生长条件(如需氧培养与厌氧培养)可有效排除非目标菌种并缩小筛选范围。
相较于液体培养,将样本划线接种于固体培养基可通过肉眼观察从背景菌落中识别目标菌落。通常需多次挑取目标菌落并重新划线接种至新鲜琼脂平板,方可获得纯培养物。成功后,可根据需求转接至液体培养基中扩增。若原始样本中目标菌种丰度过低,则需对原始样本进行多平板划线以确保分离效果。由于不同菌种生长速率及活力存在差异,此因素亦需纳入考量。

从分离板上获得纯培养物
根据实验目的的不同,获取纯培养物并非总是必需。若能在混合菌群中明确鉴定目标菌种且满足实验需求,则无需进行纯培养。然而,若需开展进一步靶向分析(如功能验证)或将细菌用于生产或食品加工等用途,则获取并维持纯培养物至关重要。
五、细菌培养的常规步骤
1)确认生长条件
先明确菌种的生长条件,包括:温度、需氧条件、湿润条件、营养条件、抗生素条件等。
2)是否需要琼脂
琼脂常用于临床初筛样本(如拭子采样)的培养,以便直观观测样本中存在的菌群并分离目标菌种;亦适用于菌落计数或单一菌落分离实验。
若以液体样本进行培养,通常需将少量样本均匀涂布于培养皿表面。若样本为拭子或其他固态载体,则需在琼脂平板表面以原始样本涂布形成初始接触区,随后使用接种环以划线法逐步稀释菌群密度,最终实现单菌落分离。
3)液体培养液培养
将少量初始样本(通常为单菌落)接种至新鲜培养基中,并置于最适生长条件下进行孵育。
此方法通常在获得纯培养物后使用,用于扩增菌体数量以支持下游应用,例如DNA提取、食品工业化生产或遗传学操作实验。
4)抗生素选择
一个应用场景是,为有效治疗感染(尤其在抗生素耐药性日益加剧的背景下),选择能有效杀灭致病菌株的抗生素至关重要。实验操作需在琼脂培养基上制备菌苔,随后放置含不同抗生素的测试纸片——若特定抗生素纸片周围形成清晰抑菌环,则表明该致病菌对该抗生素具有敏感性。
常规分子生物学实验中,仅需将目标菌株具有耐药性的抗生素加入培养基中,即可避免非目标菌株的生长。
5)选择性培养基
一些应用场景需使用选择性培养基,其可通过菌株代谢特征实现快速鉴定,其原理在于:许多菌种在生长过程中会根据细菌可分解或转化的特定化学物质,引发快速可辨的颜色变化。见上文。
六、细菌培养的常见问题
污染 – 细菌培养物的污染可能非常成问题,尤其是在未被发现的情况下。在最好的情况下,这可能意味着需要重新分离纯培养物,但在最坏的情况下,如果它发生在食品或生产环境中,可能会导致疾病和非常昂贵的补救工作。培养物污染可能来自许多来源,从原始样品本身到培养甚至储存过程。良好的无菌技术有助于避免细菌培养物的污染。
一些物种的过度生长 – 一些细菌物种很容易生长而旺盛。当试图从混合样品中分离物种时,这些生机勃勃的物种可能会过度生长并掩盖生长缓慢的目标物种的存在。为目标物种(如果已知)使用选择性培养基和最佳生长条件有助于缓解这种情况。尝试在采集样本后尽快培养样本,以确保其具有尽可能的代表性。
采样前的抗生素治疗 – 在诊断环境中,重要的是要知道采样前是否进行了抗生素治疗。如果是这种情况,未能培养特定物种可能并不表明它不是感染的原因。
不正确的生长条件 – 使用不适当或不理想的生长条件可能会阻碍或完全阻止目标菌株的生长。请务必仔细检查生长要求,或者如果使用抗生素选择,请确保为存在的抗性基因选择了正确的抗生素。
不可培养和生长缓慢的生物体– 即使是现在,一些细菌物种也无法在实验室中培养。其他的,如分枝杆菌、生长非常缓慢,可能需要数月才能成功培养,这在尝试诊断感染时尤其成问题。
七、最后
本来在写这篇推文时,预期在最后写一个示例,但是在查阅完资料后,发现简短的文字不足将一些细节概括出来,同时也很难代表各个应用场景。所以后续将详细的细菌培养示例会单独写推文。敬请关注!也可以私信【入群】,进群讨论交流!
参考文献:
1. Garrett WS, Onderdonk AB. 249 - Bacteroides, Prevotella, Porphyromonas, and Fusobacterium Species (and other medically important anaerobic Gram negative bacilli). In: Bennett JE, Dolin R, Blaser MJ, eds. Mandell, Douglas, and Bennett’s Principles and Practice of Infectious Diseases (Eighth Edition). W.B. Saunders; 2015:2773-2780. doi: 10.1016/B978-1-4557-4801-3.00249-6
2. Crespo A, Pedraz L, Astola J, Torrents E. Pseudomonas aeruginosa exhibits deficient biofilm formation in the absence of class II and III ribonucleotide reductases due to hindered anaerobic growth. Front Microbiol. 2016;7:688. doi: 10.3389/fmicb.2016.00688
3. Smith I. Mycobacterium tuberculosis pathogenesis and molecular determinants of virulence. Clin Microbiol Rev. 2003;16(3):463-496. doi: 10.1128/CMR.16.3.463-496.2003
4. Harris L, Foster S, Richards R. An introduction to Staphylococcus aureus, and techniques for identifying and quantifying S. aureus adhesins in relation to adhesion to biomaterials: review. eCM. 2002;4:39-60. doi: 10.22203/eCM.v004a04
5. von Wulffen J, Sawodny O, Feuer R. Transition of an anaerobic Escherichia coli culture to aerobiosis: Balancing mRNA and protein levels in a demand-directed dynamic flux balance analysis. PLoS One. 2016;11(7):e0158711. doi: 10.1371/journal.pone.0158711
6. Parkin A, Bowman L, Roessler MM, et al. How Salmonella oxidises H2 under aerobic conditions. FEBS Letters. 2012;586(5):536-544. doi: 10.1016/j.febslet.2011.07.044
6. Lee, Pei Yun et al. “Agarose gel electrophoresis for the separation of DNA fragments.” Journal of visualized experiments : JoVE ,62 3923. 20 Apr. 2012, doi:10.3791/3923
7.Karen Steward,An Introduction to Culturing Bacteria.January 24, 2024
8.Karen Steward,Bacterial Culture.August 22, 2022
本文由环凯转载自“生物药笔记”公众号,版权归原作者(魔鹿先生)所有,仅供学习参考,如有侵权请联系删除!
